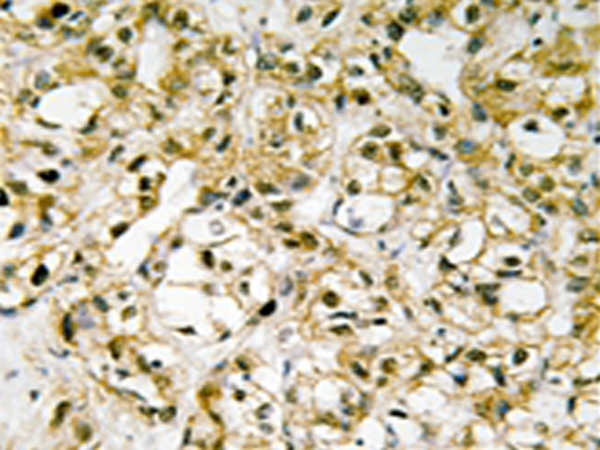

|
Background: |
This gene encodes a key mitochondrial transcription factor containing two high mobility group motifs. The encoded protein also functions in mitochondrial DNA replication and repair. Sequence polymorphisms in this gene are associated with Alzheimer's and Parkinson's diseases. There are pseudogenes for this gene on chromosomes 6, 7, and 11. Alternative splicing results in multiple transcript variants. |
|
Applications: |
IHC, IF |
|
Name of antibody: |
TFAM |
|
Immunogen: |
Synthesized peptide derived from internal of human TFAM. |
|
Full name: |
transcription factor A, mitochondrial |
|
Synonyms: |
transcription factor A, mitochondrial |
|
SwissProt: |
Q00059 |
|
IHC positive control: |
Human liver carcinoma tissue |
|
IHC Recommend dilution: |
50-100 |
|
IF positive control: |
HepG2 cells |
|
IF Recommend dilution: |
100-500 |
購物車
幫助
021-54845833/15800441009
